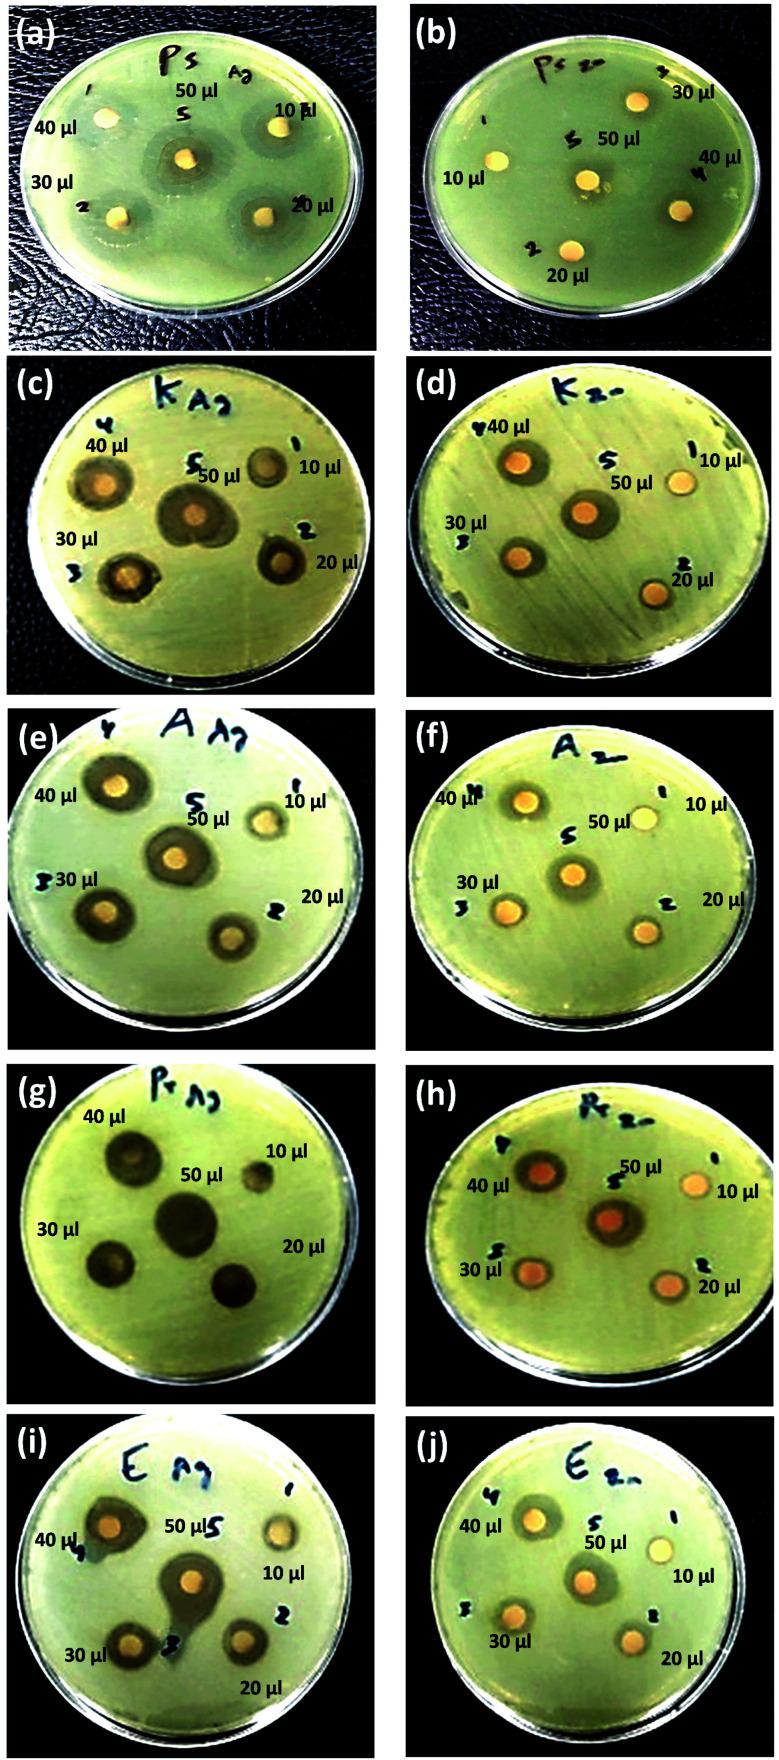
https://cdn.ncbi.nlm.nih.gov/pmc/blobs/3547/9239055/3c88536f13ca/d2ra00231k-f9.jpg
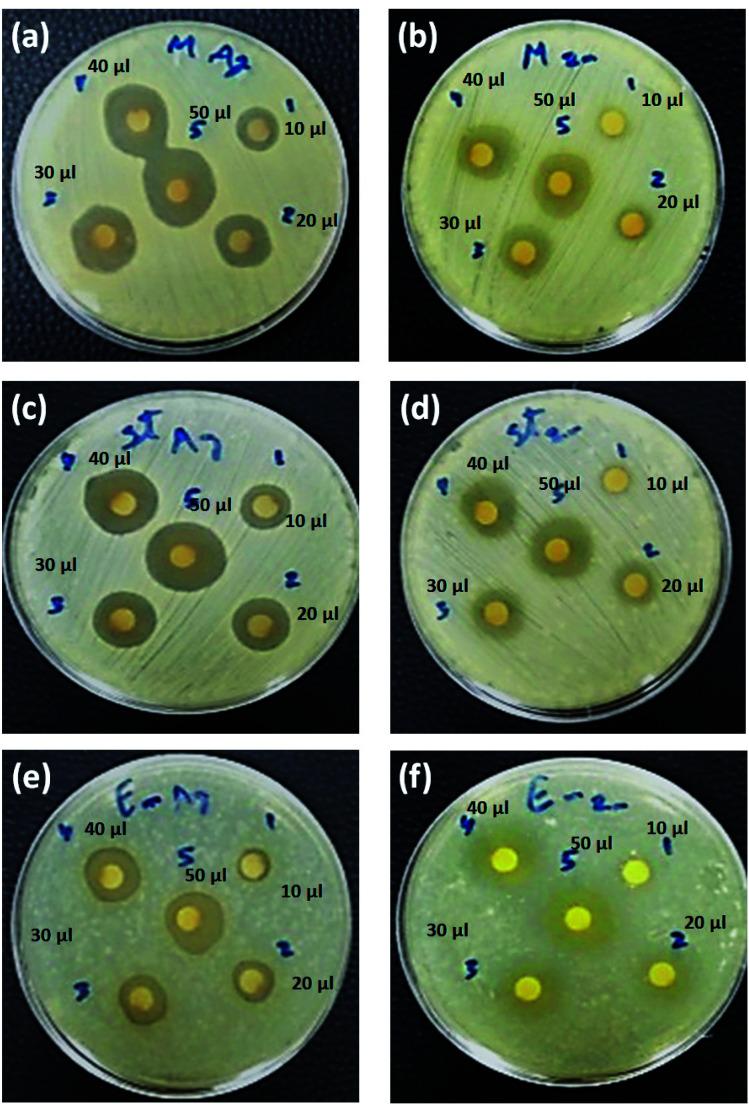
https://cdn.ncbi.nlm.nih.gov/pmc/blobs/3547/9239055/3fa138374e9d/d2ra00231k-f8.jpg

姜黄素辅助绿色合成银和氧化锌纳米结构及其对一些临床致病性多重耐药细菌的抗菌活性。
Curcumin assisted green synthesis of silver and zinc oxide nanostructures and their antibacterial activity against some clinical pathogenic multi-drug resistant bacteria.
作者信息
El-Kattan Noura, Emam Ahmed N, Mansour Ahmed S, Ibrahim Mostafa A, Abd El-Razik Ashraf B, Allam Kamilia A M, Riad Nadia Youssef, Ibrahim Samir A
机构信息
Department of Microbiology, Research Institute of Medical Entomology, General Organization for Teaching Hospitals and Institutes Giza Egypt.
Refractories, Ceramics and Building Materials Department, Advanced Materials Technology & Mineral Resources Research Institute, National Research Centre (NRC) El Bohouth St., Dokki 12622 Cairo Egypt
出版信息
RSC Adv. 2022 Jun 28;12(28):18022-18038. doi: 10.1039/d2ra00231k. eCollection 2022 Jun 14.
According to WHO warnings, the antibiotic resistance crisis is a severe health issue in the 21st century, attributed to the overuse and misuse of these medications. Consequently, the dramatic spreading rate of the drug-resistant microbial pathogens strains. The microbiological, biochemical tests and antibiotic sensitivity identified the bacteria's multi-drug resistance (MDR). About 150 different clinical samples were taken from hospitalized patients, both males, and females, ranging from 9 to 68 years. Gram-negative strains were (70.0%), while Gram-positive isolates were (30.0%). Among sixteen antibiotics, antibiotic susceptibility of imipenem was found to be the most efficient drug against most of the Gram-negative and Gram-positive isolates, followed by meropenem, depending on the culture and sensitivity results. All the experimental bacteria showed multidrug-resistant phenomena. In this study, green synthesized silver (Cur-Ag NPs) and zinc oxide (Cur-ZnO NPs) nanoparticles in the presence of curcumin extract. In addition, their physicochemical properties have been characterized using different techniques such as UV-Vis spectroscopy, transmission electron microscope (TEM), X-ray diffraction (XRD), Fourier transform infrared (FT-IR), and colloidal properties techniques. Furthermore, curcumin-capped silver nanoparticles (AgNPs) exhibited solid antimicrobial action against the experimental bacterial isolates, except . Curcumin-capped zinc oxide nanoparticles (ZnO NPs) found antimicrobial activity against all tested strains. Finally, the minimum inhibitory concentration exhibited values from 3.9 to 15.6 μg ml, which is too small compared to other traditional antibiotics. In addition, the green-synthesized Cur-Ag NPs and Cur-ZnO NPs showed good biocompatibility.
根据世界卫生组织的警告,抗生素耐药性危机是21世纪严重的健康问题,这归因于这些药物的过度使用和滥用。因此,耐药微生物病原体菌株的传播速度惊人。微生物学、生化测试和抗生素敏感性鉴定了细菌的多重耐药性(MDR)。从9至68岁的住院男性和女性患者身上采集了约150份不同的临床样本。革兰氏阴性菌株占(70.0%),而革兰氏阳性分离株占(30.0%)。在16种抗生素中,根据培养和敏感性结果,发现亚胺培南对大多数革兰氏阴性和革兰氏阳性分离株是最有效的药物,其次是美罗培南。所有实验细菌均表现出多重耐药现象。在本研究中,在姜黄素提取物存在的情况下绿色合成了银(姜黄素-银纳米颗粒)和氧化锌(姜黄素-氧化锌纳米颗粒)纳米颗粒。此外,已使用不同技术对其物理化学性质进行了表征,如紫外-可见光谱、透射电子显微镜(TEM)、X射线衍射(XRD)、傅里叶变换红外(FT-IR)和胶体性质技术。此外,姜黄素包覆的银纳米颗粒(AgNPs)对实验细菌分离株表现出强大的抗菌作用,除了……姜黄素包覆的氧化锌纳米颗粒(ZnO NPs)对所有测试菌株均有抗菌活性。最后,最低抑菌浓度的值为3.9至15.6μg/ml,与其他传统抗生素相比非常低。此外,绿色合成的姜黄素-银纳米颗粒和姜黄素-氧化锌纳米颗粒表现出良好的生物相容性。